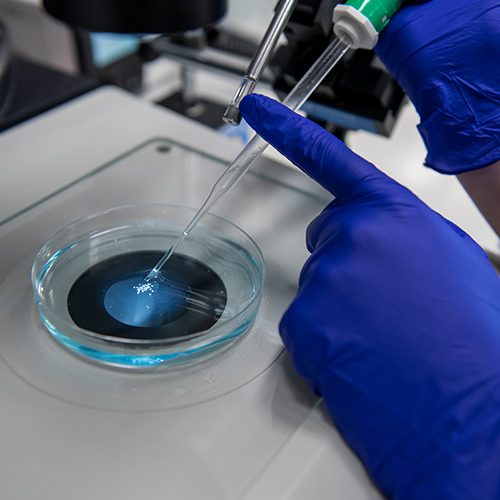
Gloved hands placing sample material in petri dish

Research Scholars
Stowers Research Scholars Program
A mentored 6-month postbaccalaureate research program that provides early stage researchers with valuable opportunities for scientific training and professional development.

Stowers Research Scholars
Stowers Research Scholars experience guided research opportunities in a Stowers laboratory and participate in a training course that will provide a structured calendar of events and training sessions associated with our internationally renown laboratories. In addition, Research Scholars have access to career development counseling and graduate school application mentoring from the staff and leadership of the Graduate School.
Research Scholars Highlights

Independent Research Project
Research Scholars have the opportunity to expand their education and skills through hands-on laboratory experiences that stress highly critical thinking. These experiences result in an independent research project that the scholars present during lab meetings.

Professional Development
The program provides academic and career counseling as well as assistance throughout the graduate school application process. Research Scholars have the opportunity to participate in a variety of workshops and seminars focusing on research and career development.

Broad Research Topics
Stowers Institute research focuses on foundational research in organisms, tissues, and cells to understand the many mechanisms underlying human health and disease. Research Scholars can choose to focus on any of the research topics from development and regeneration to genetics and genomics, molecular and cell biology or neuroscience to name a few. Scholars will also have access to collaborative Technology Centers, on-site conferences, and wellness programs.
How to apply

- Identify a lab you are interested in working in. Explore our labs here.
- Send an email to the PI of the lab as well as postbac@stowers.edu to express your interest in joining their lab as a Stowers Research Scholar.
- Once the PI has agreed to take you on as a Scholar, provide them with the documents as outlined below.
Become a Research Scholar
Applications are now open. Explore our Labs and email the Investigator you are interested in working with to begin the application process.
Explore our labsProgram Requirements
Participants must have a completed B.S. or B.A. degree in Biology, Computation, or a relevant STEM discipline. Degree must be conferred prior to the program start date.
Compensation and Benefits
The Graduate School is committed to giving each research scholar the best research experience in an unrivaled research environment. Research Scholars do not pay a fee to participate in the program and receive a competitive salary and benefits.
- Competitive pay of $18.51/hour (Please note that all appointments are for 6-month terms, renewable for up to a total of 18 months depending on satisfactory performance review and PI approval)
- Access to medical, pharmacy, and dental Insurance
What you'll need to apply
- You are required to submit the following documents to the PI lab you are interested in applying for:
- Cover Letter
- CV/Resume
- Stowers PI nominating paragraph
- This will be provided on your behalf by the Stowers PI whose lab you are interested in
- Unofficial Academic Transcripts
- Two letters of recommendation to be sent directly to the lab you are interested in joining
Frequently Asked Questions
Take a look at Research Scholars FAQ
Answers to questions asked by previous research scholars might help you during the application process.
Meet our Research Scholar

Emily Howell
B.S., Biology, Rockhurst University
Gerton Lab
Contact us via email at postbac@stowers.edu if you have questions or need additional information about the Research Scholars program.
Email us